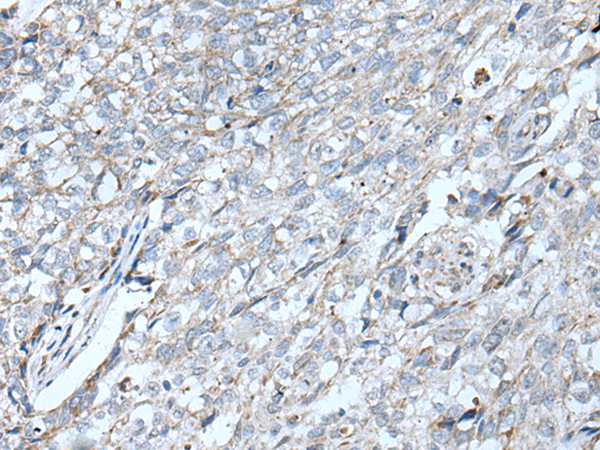

|
Background: |
This gene encodes a member of the vaccinia-related kinase (VRK) family of serine/threonine protein kinases. The encoded protein acts as an effector of signaling pathways that regulate apoptosis and tumor cell growth. Variants in this gene have been associated with schizophrenia. Alternative splicing results in multiple transcript variants that differ in their subcellular localization and biological activity. |
|
Applications: |
ELISA, WB, IHC |
|
Name of antibody: |
VRK2 |
|
Immunogen: |
Synthetic peptide of human VRK2 |
|
Full name: |
vaccinia related kinase 2 |
|
SwissProt: |
Q86Y07 |
|
ELISA Recommended dilution: |
5000-10000 |
|
IHC positive control: |
Human lung cancer and Human brain |
|
IHC Recommend dilution: |
35-200 |
|
WB Predicted band size: |
58 kDa |
|
WB Positive control: |
Human fetal liver tissue lysate |
|
WB Recommended dilution: |
500-2000 |

購物車
購物車 幫助
幫助
 021-54845833/15800441009
021-54845833/15800441009
